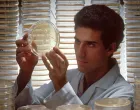
biolog, naučnik, doktor, istraživač, hemičar/National Cancer Institute

"Cvijet istine i nade" u Beču: Snažan i emotivan podsjetnik na genocid u Srebrenici

Kulturno-umjetnički performans povodom 30. godišnjice genocida u Srebrenici/Vlada TK
Na jednom od najpoznatijih trgova u Beču, Trgu Marije Terezije, sinoć je prvi put izveden kulturno-umjetnički performans pod nazivom "Cvijet istine i nade".
Ovim se na snažan i emotivan način podsjeća na genocid počinjen nad Bošnjacima "Zaštićene zone UN-a" Srebrenice tokom agresije na Bosnu i Hercegovinu 90-ih godina.
Jedinstveni umjetnički čin, čiji je cilj očuvanje kolektivnog sjećanja i borba protiv zaborava, okupio je brojne građane, predstavnike bh. dijaspore, austrijskih institucija, međunarodnih organizacija i javnog života. Kroz umjetnost, emociju i simboliku, poslana je snažna poruka istine, pravde i odgovornosti.
Performans je rezultat ideje koja dolazi sa Univerziteta u Tuzli, od profesora sociologije genocida prof. dr. Midhata Čauševića. Scenario potpisuje prof. Irfan Kasumović sa Akademije dramskih umjetnosti, dok su izvedbu realizirali glumci Akademije, uz podršku djece iz hora iz Srebrenice. Muzički segment kreirao je prof. Miralem Mejremić, čime je kompletirana umjetnička cjelina snažne poruke i simbolike.
U realizaciji tog projekta značajnu ulogu imalo je i udruženje građana Moja adresa Srebrenica, kao i Nermin Alivuković, a posebnu podršku pružila je Vlada TK, prepoznavši važnost promicanja kulture sjećanja i međunarodne afirmacije istine o genocidu.
Manifestaciji je prisustvovao i premijer Tuzlanskog kantona Irfan Halilagić.
- Velika čast mi je biti dio ovakvog tima. Poruka koju nosimo i nastojimo širiti ovim djelom je da moramo raditi svi zajedno na podsjećanju, na pamćenju - da se više nikada i nikome ne ponovi Srebrenica, kazao je premijer Halilagić, saopćeno je iz Odjeljenja za informiranje TK.